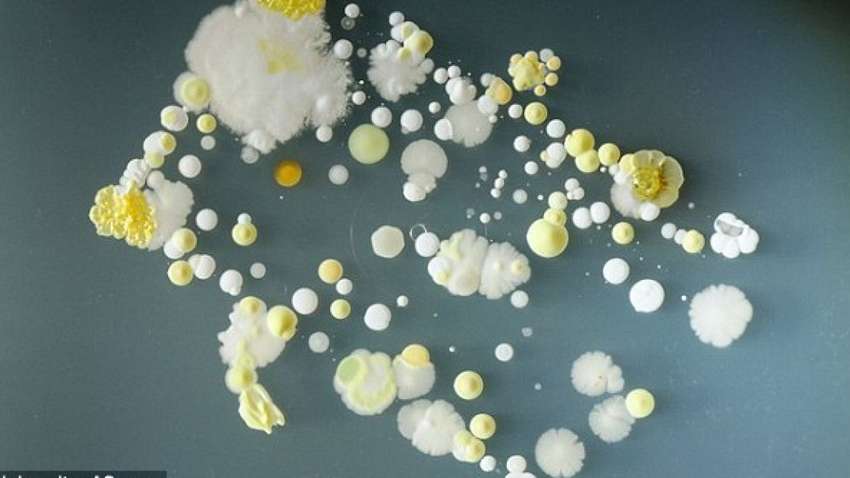
На поверхности смартфонов обнаружили опасные бактерии

Рубрики
МЕНЮ
На поверхности смартфонов обнаружили опасные бактерии
40% смартфонов были загрязнены бактерией золотистый стафилококк

Светлана Шкурупий
Исследователи
из Западного Университета в Сан-Паулу (Бразилия) нашли на смартфонах
студентов-медиков множество опасных бактерий. Об этом сообщает "Medicalxpress".
Учёные
взяли образцы с поверхностей 100 мобильных телефонов студентов факультетов
биомедицины (20), фармакологии (20), стоматологии (20), питания (20) и
сестринского дела (20).
Оказалось,
что 85% выделенных микробов имеют устойчивость к пенициллину, а 50% способны
прилипать к поверхностям. Это значит, что использование загрязнённых телефонов
в больнице может обернуться тяжёлыми последствиями для персонала и пациентов.
Кроме
того, на 40% смартфонов обнаружили бактерию S. aureus, или золотистый
стафилококк. Она может вызывать целый спектр заболеваний, начиная от угрей и
фурункулов, и заканчивая пневмонией или менингитом.
Отмечается,
что сотовые телефоны, используемые в медицинских учреждениях, позволяют передавать
бактерии, которые несут в себе гены вирулентности и резистентности, способствуют повышению уровня заражения, а также увеличению заболеваемости / смертности от
этих инфекций.
"Смартфоны служат резервуаром микробов, которые, как известно, вызывают
внутрибольничные инфекции и могут передаваться пациентам через руки медицинских
работников", — сообщила профессор Западного университета Сан-Паулу Лиззиан
Кретли.
Напомним, ранее "Комментарии" сообщали о том, что ученые из США обнаружили в организме мышей вирус, который способен укреплять способности иммунитета.
Источник: https://medicalxpress.com/news/2019-06-dissemination-pathogenic-bacteria-university-student.html
Читайте Comments.ua в Google News
Новости партнеров



